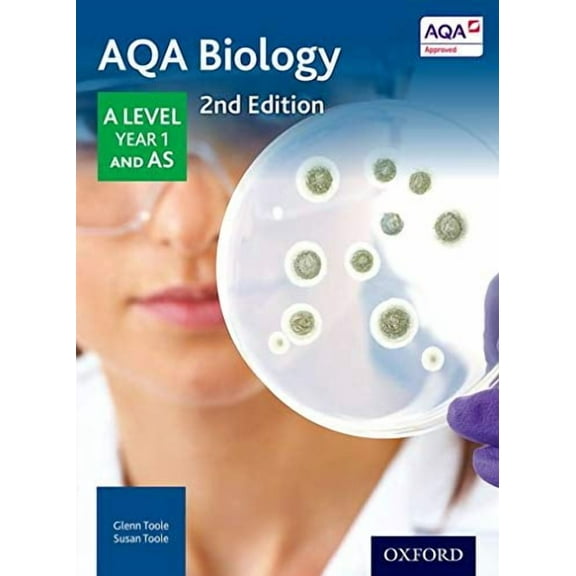
AQA Biology: A Level Year 1 and AS

Hero image 0 of Holt Biology : Student Edition 2008, 0 of 1
Current price is USD$86.84
Price when purchased online
Out of stock
How do you want your item?
Out of stock
About this item
Customer ratings & reviews
0 ratings|0 reviews
This item does not have any reviews yet
Related pages
- Campbell Biology 11th Edition
- Education Research Books
- Knowledgebird Publishing
- Comparative Education Books
- Educational Research
- Archives & Special Libraries Books
- Human Geography Books
- Books for Librarians
- Research Triangle Publishing
- Biology Princeton
- Campbell Biology Pearson
- General Library & Information Science Books